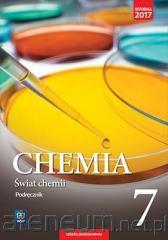

Sortuj według:
Wydawnictwo/Producent:
Kategoria:
Etykieta:
Dostępność:

59.99zł
5%

35.00zł
5%

9788366814493
broszurowa
2017
49.90zł
5%
9788302168765
A176801
broszurowa
2017
50.21zł
5%

9788302174247
A176814
broszurowa
2018
21.90zł
5%

9788302174230
A176813
broszurowa
2018
50.21zł
5%

9788382703979
broszurowa
2025
2025-04-23
120.00zł
5%

29.99zł
5%

49.99zł
5%

49.99zł
5%

44.99zł
5%

39.99zł
5%

9788381512077
broszurowa
2019
2019-10-30
34.99zł
5%

49.99zł
5%

9788383602523
twarda
2025
2025-06-11
79.99zł
5%

9788367867207
broszurowa
2024
2024-01-16
49.90zł
5%

9788382718089
etui kartonowe
2022
2022-10-19
32.95zł
5%

34.99zł
5%

9788302131783
A155549
broszurowa
2013
13.80zł
5%

9788320619188
twarda
2011
69.00zł
5%

9788322451960
20955
broszurowa
2023
2023-12-06
24.90zł
5%

49.99zł
5%

49.99zł
5%

9788381519489
broszurowa
2025
2025-02-17
59.99zł
5%

9788367787192
broszurowa
2023
2023-07-17
39.90zł
5%

9788384000465
broszurowa
2025
2025-08-13
49.99zł
5%

9788367706230
broszurowa
2023
37.00zł
5%

9788302173141
A178314
broszurowa
2018
29.90zł
5%

9788380836341
broszurowa
2017
2017-08-27
27.00zł
5%

99.00zł
5%

47.90zł
5%

29.99zł
5%

25.00zł
5%

9788381028332
2024
2024-06-08
85.00zł
5%

9788383602158
zintegrowana
2025
2025-05-07
79.99zł
5%

9788364443039
broszurowa
2019
59.00zł
5%

9788377636367
broszurowa
2022
14.90zł
5%

9788380111547
broszurowa
2021
2021-06-17
28.00zł
5%

54.90zł
5%

9788322452202
20978
broszurowa
2025
2025-09-02
89.00zł
5%

9788322450161
20772010
broszurowa
2018
2018-10-29
32.00zł
5%

44.90zł
5%

44.70zł
5%

9788383348032
folia
2024
44.90zł
5%

9788384001080
broszurowa
2025
2025-11-12
49.99zł
5%

9788381518376
broszurowa
2024
2024-05-29
44.99zł
5%

39.99zł
5%

49.99zł
5%

9788382081480
twarda
2023
2023-03-16
29.90zł
5%

52.00zł
5%